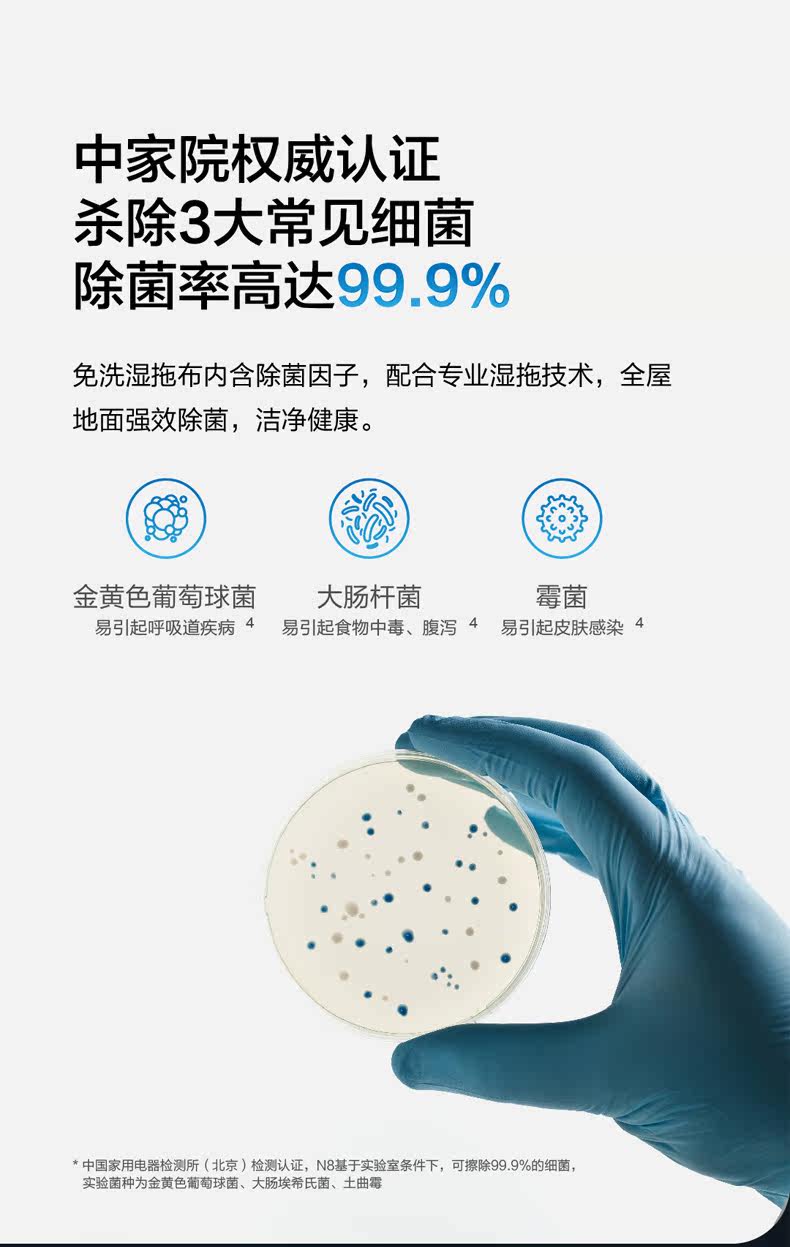

- Таобао
- Техника
- Бытовая техника
- Электрические щетки для уборки
- 628890172861
Умный робот для домашнего использования, автоматический пылесос, полностью автоматический

Цена: 47 889руб. (¥2299)
Артикул: 628890172861
Вес товара: ~0.7 кг. Указан усредненный вес, который может отличаться от фактического. Не включен в цену, оплачивается при получении.
Описание товараPHA+PGEgaHJlZj0iaHR0cDovL2Ftb3MuYWxpY2RuLmNvbS9tc2cuYXc/dj0yJmFtcDt1aWQ9JUU3JUE3JTkxJUU2JUIyJTgzJUU2JTk2JUFGJUU1JUFFJTg3JUU3JUE3JTgwJUU0JUI4JTkzJUU1JThEJTk2JUU1JUJBJTk3JmFtcDtzaXRlPWNudGFvYmFvJmFtcDtzPTEmYW1wO2NoYXJzZXQ9dXRmLTgiIHRhcmdldD0iX2JsYW5rIj48aW1nIHNyYz0iaHR0cHM6Ly9pbWcuYWxpY2RuLmNvbS9pbWdleHRyYS9pMy8yMjA2Mzg0MDU3NTg3L08xQ04wMVpQRHFuejI1dXRhdkx4WldLXyEhMjIwNjM4NDA1NzU4Ny5qcGciIGFsaWduPSJhYnNtaWRkbGUiPjwvYT48YSBocmVmPSJodHRwOi8vYW1vcy5hbGljZG4uY29tL21zZy5hdz92PTImYW1wO3VpZD0lRTclQTclOTElRTYlQjIlODMlRTYlOTYlQUYlRTUlQUUlODclRTclQTclODAlRTQlQjglOTMlRTUlOEQlOTYlRTUlQkElOTcmYW1wO3NpdGU9Y250YW9iYW8mYW1wO3M9MSZhbXA7Y2hhcnNldD11dGYtOCIgdGFyZ2V0PSJfYmxhbmsiPjxpbWcgc3JjPSJodHRwczovL2ltZy5hbGljZG4uY29tL2ltZ2V4dHJhL2kxLzIyMDYzODQwNTc1ODcvTzFDTjAxeno2NmNNMjV1dGFWd21pcHNfISEyMjA2Mzg0MDU3NTg3LmpwZyIgYWxpZ249ImFic21pZGRsZSI+PGltZyBzcmM9Imh0dHBzOi8vaW1nLmFsaWNkbi5jb20vaW1nZXh0cmEvaTEvMjIwNjM4NDA1NzU4Ny9PMUNOMDFaVkZzRVQyNXV0YXd1Z3RHR18hITIyMDYzODQwNTc1ODcuanBnIiBhbGlnbj0iYWJzbWlkZGxlIj48L2E+PGltZyBzcmM9Imh0dHBzOi8vaW1nLmFsaWNkbi5jb20vaW1nZXh0cmEvaTMvMjIwNjM4NDA1NzU4Ny9PMUNOMDF2RVR5Nm4yNXV0YTJnbE5kZF8hITIyMDYzODQwNTc1ODcuanBnIiBhbGlnbj0iYWJzbWlkZGxlIj48YSBocmVmPSJodHRwOi8vYW1vcy5hbGljZG4uY29tL21zZy5hdz92PTImYW1wO3VpZD0lRTclQTclOTElRTYlQjIlODMlRTYlOTYlQUYlRTUlQUUlODclRTclQTclODAlRTQlQjglOTMlRTUlOEQlOTYlRTUlQkElOTcmYW1wO3NpdGU9Y250YW9iYW8mYW1wO3M9MSZhbXA7Y2hhcnNldD11dGYtOCIgdGFyZ2V0PSJfYmxhbmsiPjxpbWcgc3JjPSJodHRwczovL2ltZy5hbGljZG4uY29tL2ltZ2V4dHJhL2kxLzIyMDYzODQwNTc1ODcvTzFDTjAxNVZHaWRvMjV1dGFnZDVRdThfISEyMjA2Mzg0MDU3NTg3LmpwZyIgYWxpZ249ImFic21pZGRsZSI+PC9hPjxhIGhyZWY9Imh0dHA6Ly9hbW9zLmFsaWNkbi5jb20vbXNnLmF3P3Y9MiZhbXA7dWlkPSVFNyVBNyU5MSVFNiVCMiU4MyVFNiU5NiVBRiVFNSVBRSU4NyVFNyVBNyU4MCVFNCVCOCU5MyVFNSU4RCU5NiVFNSVCQSU5NyZhbXA7c2l0ZT1jbnRhb2JhbyZhbXA7cz0xJmFtcDtjaGFyc2V0PXV0Zi04IiB0YXJnZXQ9Il9ibGFuayI+PGltZyBzcmM9Imh0dHBzOi8vaW1nLmFsaWNkbi5jb20vaW1nZXh0cmEvaTIvMjIwNjM4NDA1NzU4Ny9PMUNOMDFTT3VaVzEyNXV0YTR0MU5hRl8hITIyMDYzODQwNTc1ODcuanBnIiBhbGlnbj0iYWJzbWlkZGxlIj48L2E+PGJyPjxhIGhyZWY9Imh0dHA6Ly9hbW9zLmFsaWNkbi5jb20vbXNnLmF3P3Y9MiZhbXA7dWlkPSVFNyVBNyU5MSVFNiVCMiU4MyVFNiU5NiVBRiVFNSVBRSU4NyVFNyVBNyU4MCVFNCVCOCU5MyVFNSU4RCU5NiVFNSVCQSU5NyZhbXA7c2l0ZT1jbnRhb2JhbyZhbXA7cz0xJmFtcDtjaGFyc2V0PXV0Zi04IiB0YXJnZXQ9Il9ibGFuayI+PGltZyBzcmM9Imh0dHBzOi8vaW1nLmFsaWNkbi5jb20vaW1nZXh0cmEvaTEvMjIwNjM4NDA1NzU4Ny9PMUNOMDFZM1pUVDMyNXV0YTVGcm1pMl8hITIyMDYzODQwNTc1ODcuanBnIiBhbGlnbj0iYWJzbWlkZGxlIj48aW1nIHNyYz0iaHR0cHM6Ly9pbWcuYWxpY2RuLmNvbS9pbWdleHRyYS9pMS8yMjA2Mzg0MDU3NTg3L08xQ04wMXlLUUFoNDI1dXRhNTlHdlpqXyEhMjIwNjM4NDA1NzU4Ny5qcGciIGFsaWduPSJhYnNtaWRkbGUiPjxpbWcgc3JjPSJodHRwczovL2ltZy5hbGljZG4uY29tL2ltZ2V4dHJhL2kxLzIyMDYzODQwNTc1ODcvTzFDTjAxWjRBbnpuMjV1dGFGOVBEN3VfISEyMjA2Mzg0MDU3NTg3LmpwZyIgYWxpZ249ImFic21pZGRsZSI+PC9hPjxicj48YSBocmVmPSJodHRwOi8vYW1vcy5hbGljZG4uY29tL21zZy5hdz92PTImYW1wO3VpZD0lRTclQTclOTElRTYlQjIlODMlRTYlOTYlQUYlRTUlQUUlODclRTclQTclODAlRTQlQjglOTMlRTUlOEQlOTYlRTUlQkElOTcmYW1wO3NpdGU9Y250YW9iYW8mYW1wO3M9MSZhbXA7Y2hhcnNldD11dGYtOCIgdGFyZ2V0PSJfYmxhbmsiPjxpbWcgc3JjPSJodHRwczovL2ltZy5hbGljZG4uY29tL2ltZ2V4dHJhL2kzLzIyMDYzODQwNTc1ODcvTzFDTjAxV3RUSzBUMjV1dGFTRmdVSWlfISEyMjA2Mzg0MDU3NTg3LmpwZyIgYWxpZ249ImFic21pZGRsZSI+PC9hPjxpbWcgc3JjPSJodHRwczovL2ltZy5hbGljZG4uY29tL2ltZ2V4dHJhL2kxLzIyMDYzODQwNTc1ODcvTzFDTjAxOEh4YmxOMjV1dGEzU1dpdHpfISEyMjA2Mzg0MDU3NTg3LmpwZyIgYWxpZ249ImFic21pZGRsZSI+PGltZyBzcmM9Imh0dHBzOi8vaW1nLmFsaWNkbi5jb20vaW1nZXh0cmEvaTMvMjIwNjM4NDA1NzU4Ny9PMUNOMDFPa1FOZ2oyNXV0YTNPQkZBMl8hITIyMDYzODQwNTc1ODcuanBnIiBhbGlnbj0iYWJzbWlkZGxlIj48aW1nIHNyYz0iaHR0cHM6Ly9pbWcuYWxpY2RuLmNvbS9pbWdleHRyYS9pMy8yMjA2Mzg0MDU3NTg3L08xQ04wMUdFTmFpNjI1dXRaem9mVGRvXyEhMjIwNjM4NDA1NzU4Ny5qcGciIGFsaWduPSJhYnNtaWRkbGUiPjxpbWcgc3JjPSJodHRwczovL2ltZy5hbGljZG4uY29tL2ltZ2V4dHJhL2kxLzIyMDYzODQwNTc1ODcvTzFDTjAxUVdSY2Y2MjV1dGExWmtURTZfISEyMjA2Mzg0MDU3NTg3LmpwZyIgYWxpZ249ImFic21pZGRsZSI+PGltZyBzcmM9Imh0dHBzOi8vaW1nLmFsaWNkbi5jb20vaW1nZXh0cmEvaTIvMjIwNjM4NDA1NzU4Ny9PMUNOMDFHczMxcWYyNXV0WnpkM09DbF8hITIyMDYzODQwNTc1ODcuanBnIiBhbGlnbj0iYWJzbWlkZGxlIj48aW1nIHNyYz0iaHR0cHM6Ly9pbWcuYWxpY2RuLmNvbS9pbWdleHRyYS9pNC8yMjA2Mzg0MDU3NTg3L08xQ04wMXZKZWx2aDI1dXRhMmxjTnNGXyEhMjIwNjM4NDA1NzU4Ny5qcGciIGFsaWduPSJhYnNtaWRkbGUiPjxpbWcgc3JjPSJodHRwczovL2ltZy5hbGljZG4uY29tL2ltZ2V4dHJhL2kyLzIyMDYzODQwNTc1ODcvTzFDTjAxMkdxTU9BMjV1dFp3WExsYjhfISEyMjA2Mzg0MDU3NTg3LmpwZyIgYWxpZ249ImFic21pZGRsZSI+PGltZyBzcmM9Imh0dHBzOi8vaW1nLmFsaWNkbi5jb20vaW1nZXh0cmEvaTQvMjIwNjM4NDA1NzU4Ny9PMUNOMDFWNnk3ZDgyNXV0YTNPQ2FabF8hITIyMDYzODQwNTc1ODcuanBnIiBhbGlnbj0iYWJzbWlkZGxlIj48aW1nIHNyYz0iaHR0cHM6Ly9pbWcuYWxpY2RuLmNvbS9pbWdleHRyYS9pMS8yMjA2Mzg0MDU3NTg3L08xQ04wMVU5Qjg0SjI1dXRaejVhODlBXyEhMjIwNjM4NDA1NzU4Ny5qcGciIGFsaWduPSJhYnNtaWRkbGUiPjxpbWcgc3JjPSJodHRwczovL2ltZy5hbGljZG4uY29tL2ltZ2V4dHJhL2kzLzIyMDYzODQwNTc1ODcvTzFDTjAxam1FdHVIMjV1dFp6MDdFNGVfISEyMjA2Mzg0MDU3NTg3LmpwZyIgYWxpZ249ImFic21pZGRsZSI+PGltZyBzcmM9Imh0dHBzOi8vaW1nLmFsaWNkbi5jb20vaW1nZXh0cmEvaTQvMjIwNjM4NDA1NzU4Ny9PMUNOMDFlbTVCR0UyNXV0WnowOHlEU18hITIyMDYzODQwNTc1ODcuanBnIiBhbGlnbj0iYWJzbWlkZGxlIj48aW1nIHNyYz0iaHR0cHM6Ly9pbWcuYWxpY2RuLmNvbS9pbWdleHRyYS9pMS8yMjA2Mzg0MDU3NTg3L08xQ04wMXFvdkFvWDI1dXRhMXRYcDB2XyEhMjIwNjM4NDA1NzU4Ny5qcGciIGFsaWduPSJhYnNtaWRkbGUiPjxpbWcgc3JjPSJodHRwczovL2ltZy5hbGljZG4uY29tL2ltZ2V4dHJhL2kxLzIyMDYzODQwNTc1ODcvTzFDTjAxYmhCQkhjMjV1dFp2UVRERHFfISEyMjA2Mzg0MDU3NTg3LmpwZyIgYWxpZ249ImFic21pZGRsZSI+PGltZyBzcmM9Imh0dHBzOi8vaW1nLmFsaWNkbi5jb20vaW1nZXh0cmEvaTIvMjIwNjM4NDA1NzU4Ny9PMUNOMDFPTXYyaVAyNXV0YTNPR1kySl8hITIyMDYzODQwNTc1ODcuanBnIiBhbGlnbj0iYWJzbWlkZGxlIj48aW1nIHNyYz0iaHR0cHM6Ly9pbWcuYWxpY2RuLmNvbS9pbWdleHRyYS9pMi8yMjA2Mzg0MDU3NTg3L08xQ04wMUNJQ2NkaTI1dXRaejVjc2xFXyEhMjIwNjM4NDA1NzU4Ny5qcGciIGFsaWduPSJhYnNtaWRkbGUiPjxpbWcgc3JjPSJodHRwczovL2ltZy5hbGljZG4uY29tL2ltZ2V4dHJhL2kzLzIyMDYzODQwNTc1ODcvTzFDTjAxb2pKWW9nMjV1dFp5ajBST2NfISEyMjA2Mzg0MDU3NTg3LmpwZyIgYWxpZ249ImFic21pZGRsZSI+PGltZyBzcmM9Imh0dHBzOi8vaW1nLmFsaWNkbi5jb20vaW1nZXh0cmEvaTEvMjIwNjM4NDA1NzU4Ny9PMUNOMDFFTmxZSEMyNXV0Wnpva21XRl8hITIyMDYzODQwNTc1ODcuanBnIiBhbGlnbj0iYWJzbWlkZGxlIj48aW1nIHNyYz0iaHR0cHM6Ly9pbWcuYWxpY2RuLmNvbS9pbWdleHRyYS9pNC8yMjA2Mzg0MDU3NTg3L08xQ04wMXQ5WlhrMzI1dXRhMVpzbkszXyEhMjIwNjM4NDA1NzU4Ny5qcGciIGFsaWduPSJhYnNtaWRkbGUiPjxpbWcgc3JjPSJodHRwczovL2ltZy5hbGljZG4uY29tL2ltZ2V4dHJhL2kyLzIyMDYzODQwNTc1ODcvTzFDTjAxSWVkOXJmMjV1dGE0RUdUa1JfISEyMjA2Mzg0MDU3NTg3LmpwZyIgYWxpZ249ImFic21pZGRsZSI+PGltZyBzcmM9Imh0dHBzOi8vaW1nLmFsaWNkbi5jb20vaW1nZXh0cmEvaTIvMjIwNjM4NDA1NzU4Ny9PMUNOMDFpSGJMUXYyNXV0YTNPSmxvOF8hITIyMDYzODQwNTc1ODcuanBnIiBhbGlnbj0iYWJzbWlkZGxlIj48aW1nIHNyYz0iaHR0cHM6Ly9pbWcuYWxpY2RuLmNvbS9pbWdleHRyYS9pNC8yMjA2Mzg0MDU3NTg3L08xQ04wMWJBcjZvSzI1dXRhM09KeUpjXyEhMjIwNjM4NDA1NzU4Ny5qcGciIGFsaWduPSJhYnNtaWRkbGUiPjxpbWcgc3JjPSJodHRwczovL2ltZy5hbGljZG4uY29tL2ltZ2V4dHJhL2kxLzIyMDYzODQwNTc1ODcvTzFDTjAxUzc3dkJjMjV1dFp6NWR0SENfISEyMjA2Mzg0MDU3NTg3LmpwZyIgYWxpZ249ImFic21pZGRsZSI+PGltZyBzcmM9Imh0dHBzOi8vaW1nLmFsaWNkbi5jb20vaW1nZXh0cmEvaTEvMjIwNjM4NDA1NzU4Ny9PMUNOMDFaYWtzZ1IyNXV0YTJsamhXeF8hITIyMDYzODQwNTc1ODcuanBnIiBhbGlnbj0iYWJzbWlkZGxlIj48aW1nIHNyYz0iaHR0cHM6Ly9pbWcuYWxpY2RuLmNvbS9pbWdleHRyYS9pMi8yMjA2Mzg0MDU3NTg3L08xQ04wMU5ISVhHOTI1dXRhMVp1d1hMXyEhMjIwNjM4NDA1NzU4Ny5qcGciIGFsaWduPSJhYnNtaWRkbGUiPjxpbWcgc3JjPSJodHRwczovL2ltZy5hbGljZG4uY29tL2ltZ2V4dHJhL2kxLzIyMDYzODQwNTc1ODcvTzFDTjAxMzdQNlVuMjV1dGEwdG5DeEJfISEyMjA2Mzg0MDU3NTg3LmpwZyIgYWxpZ249ImFic21pZGRsZSI+PGltZyBzcmM9Imh0dHBzOi8vaW1nLmFsaWNkbi5jb20vaW1nZXh0cmEvaTMvMjIwNjM4NDA1NzU4Ny9PMUNOMDFxblJZUDkyNXV0YTRFSFVKTV8hITIyMDYzODQwNTc1ODcuanBnIiBhbGlnbj0iYWJzbWlkZGxlIj48L3A+
Продавец:科沃斯宇秀专卖店
Адрес:Чжэцзян
Рейтинг:

Всего отзывов:0
Положительных:0
Выберите вариацию / цвет
- Б е л, скупой,
Добавить в корзину